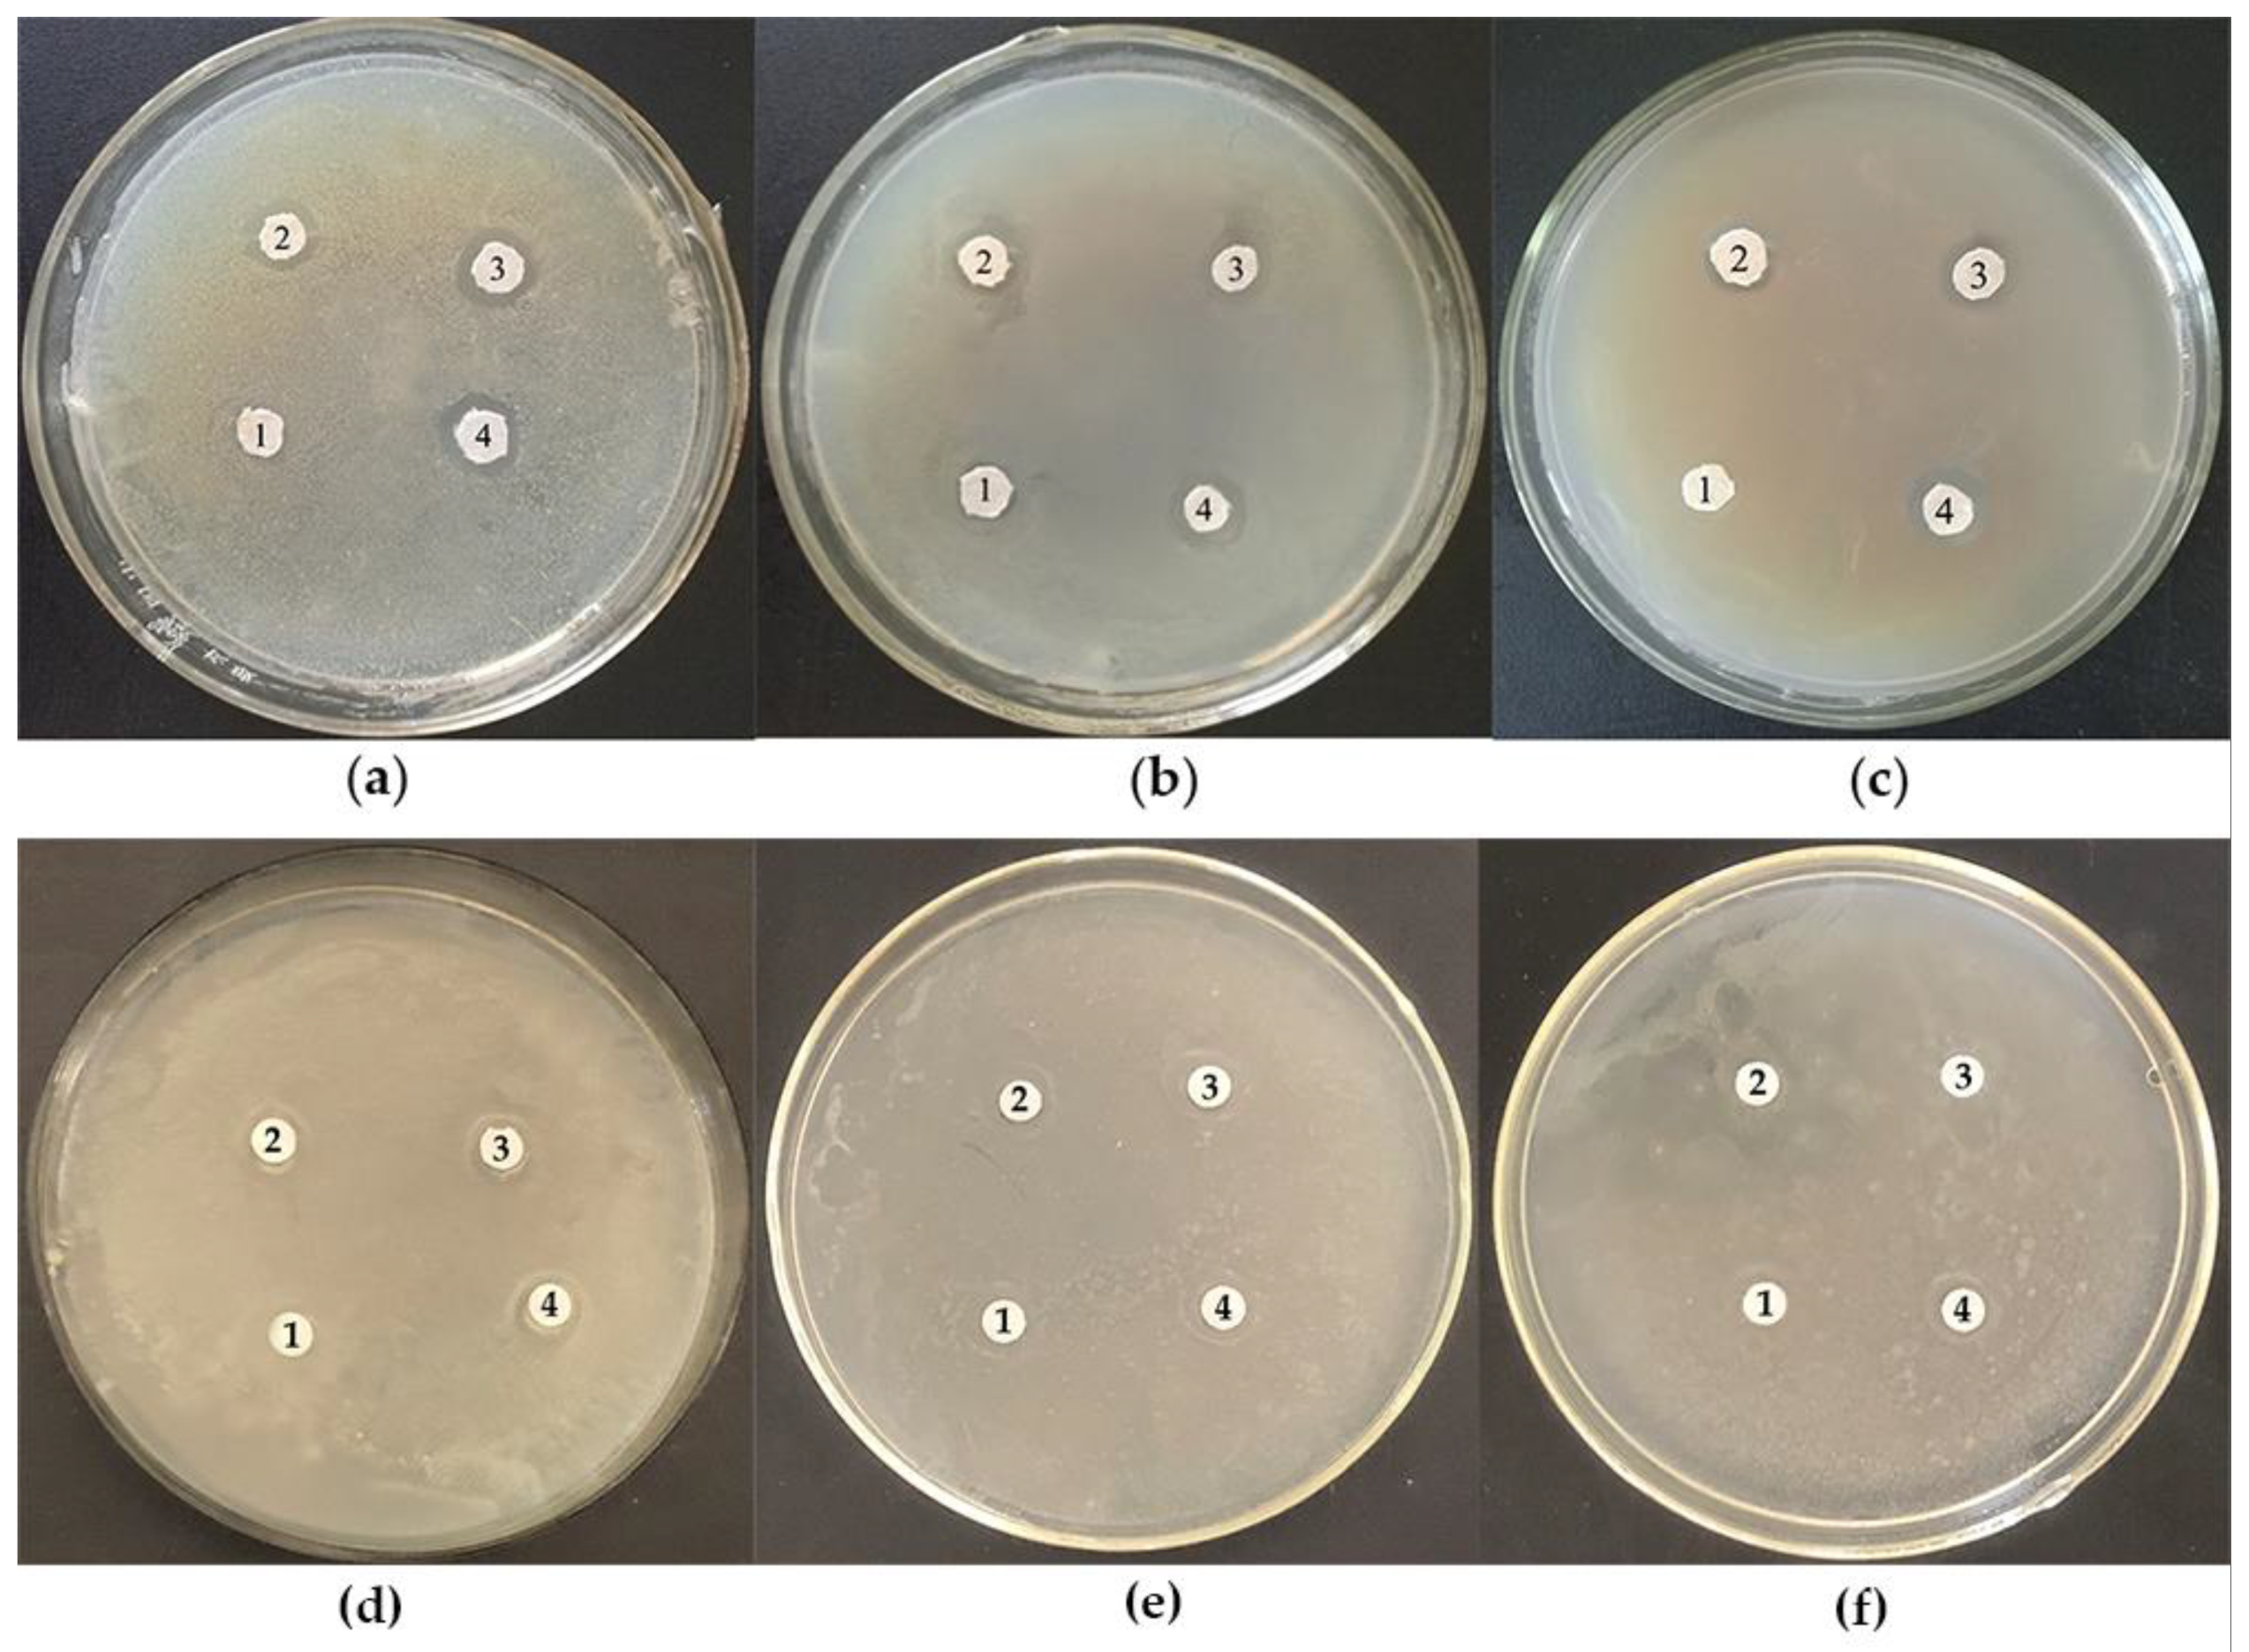
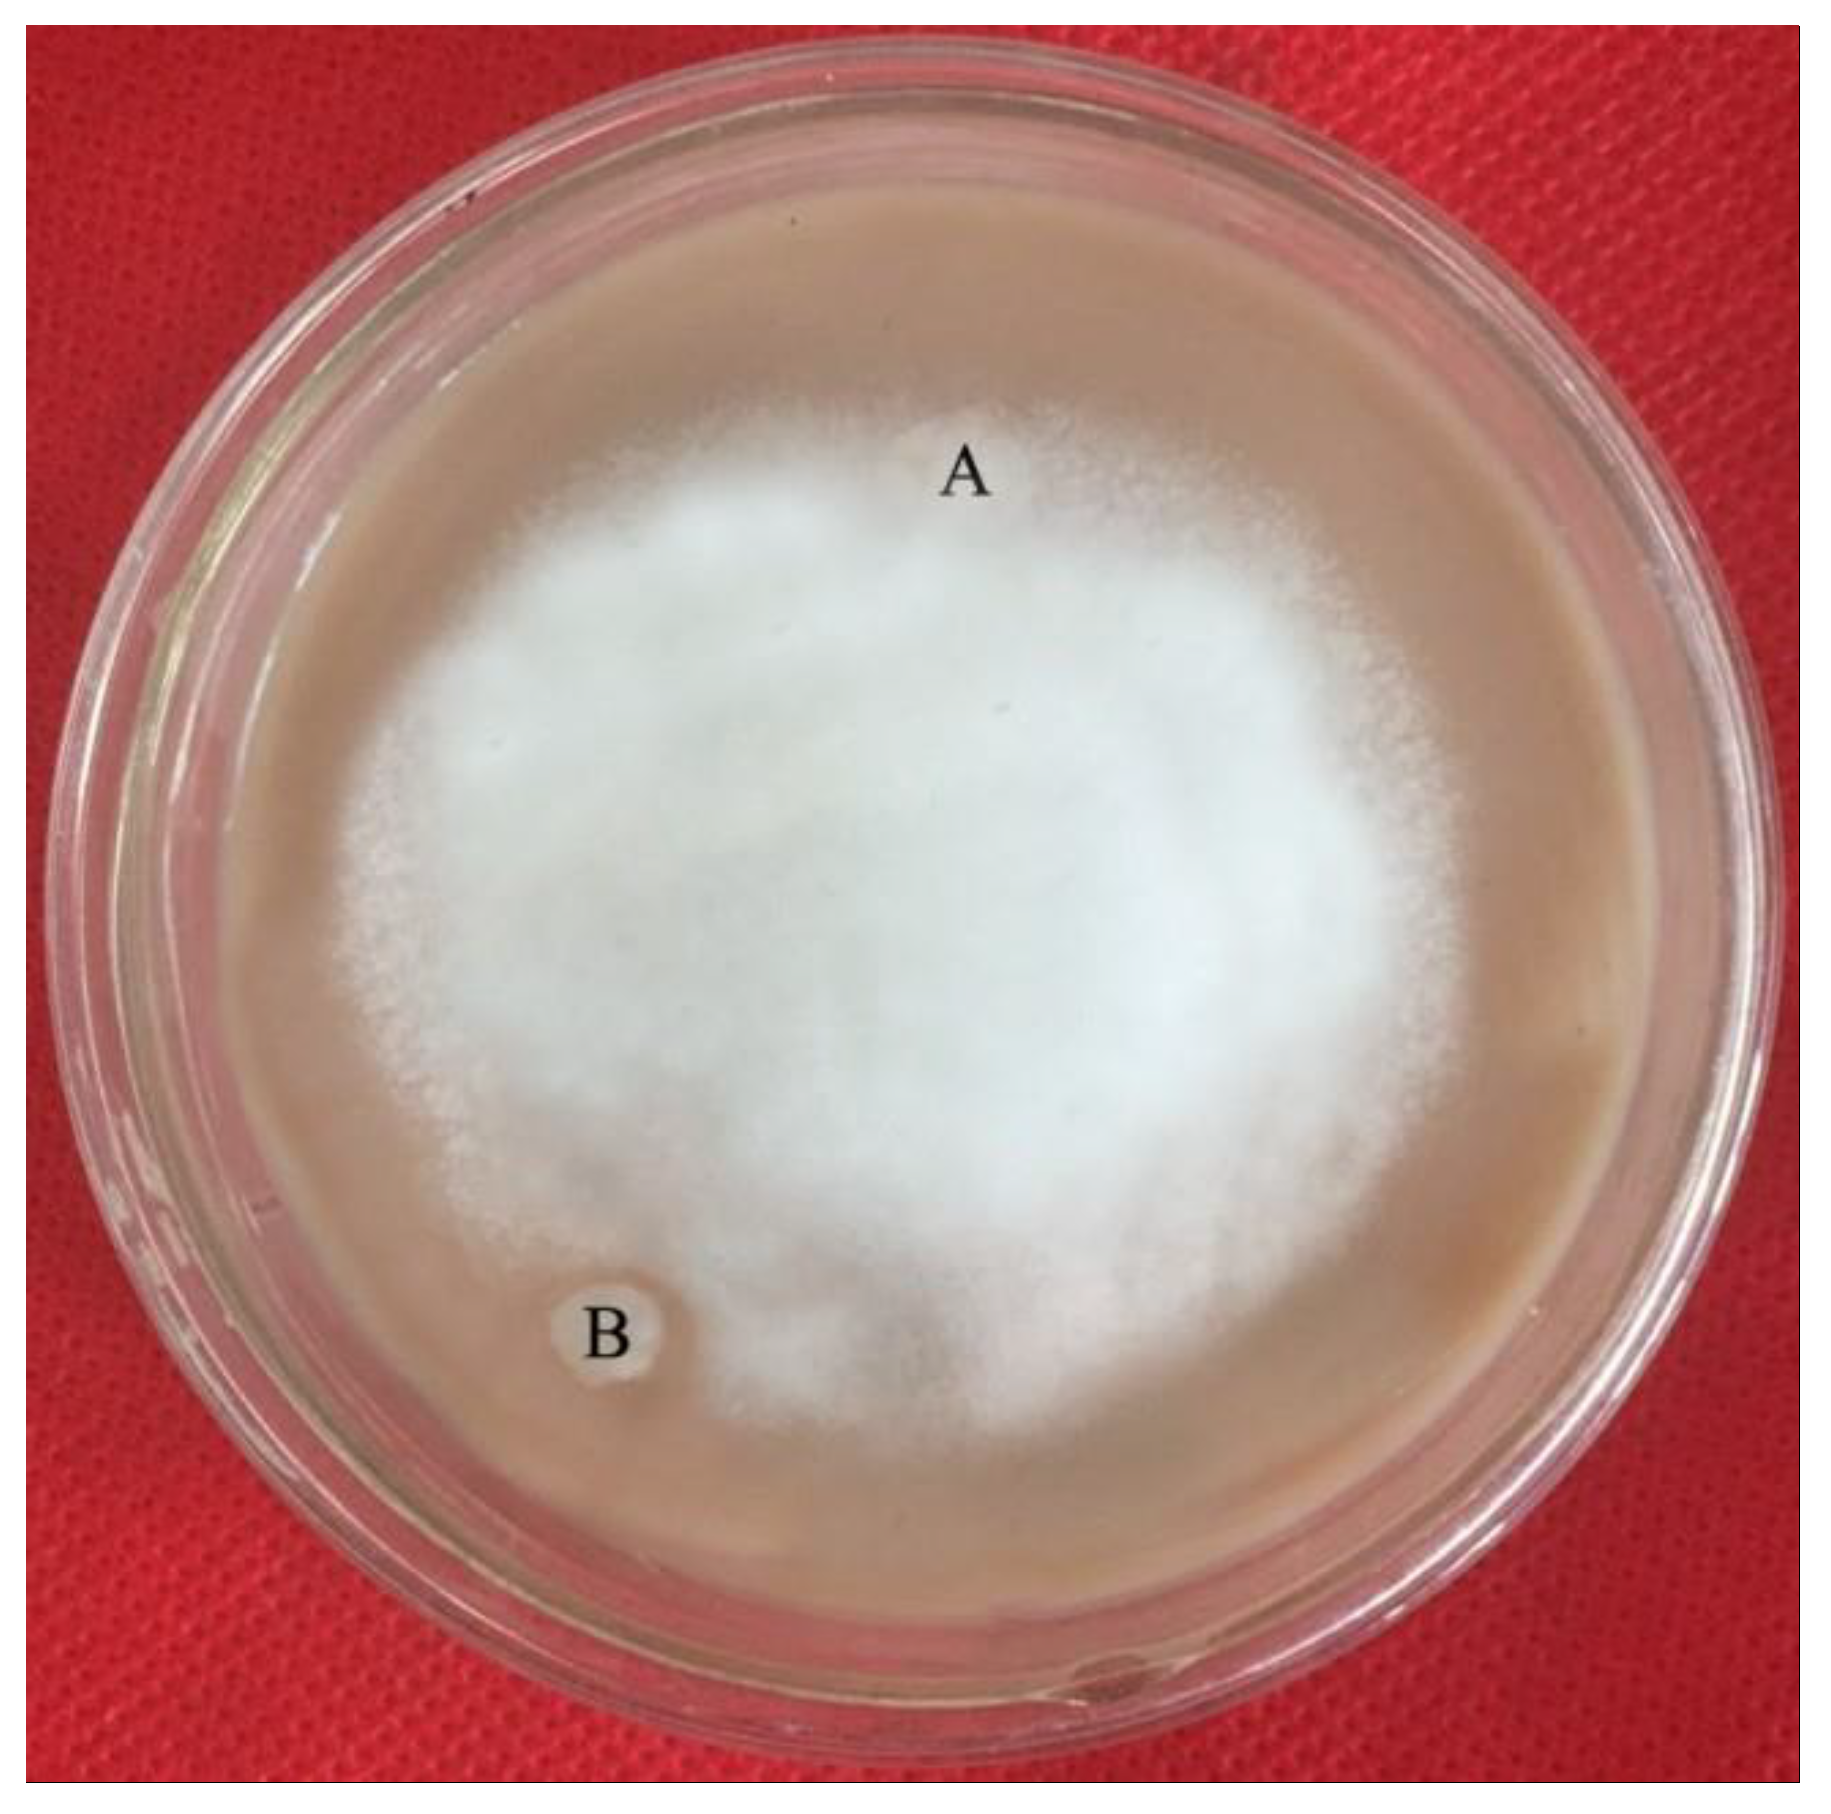

Two-Step Isolation, Purification, and Characterization of Lectin from Zihua Snap Bean (Phaseolus vulgaris) Seeds
Abstract
1. Introduction
2. Materials and Methods
2.1. Instruments
2.2. Reagents
2.3. Extraction and Purification of Zihua Snap Bean Lectin
2.4. Determination of the Hemagglutinating Activity
2.5. The Properties Experiment of the Zihua Snap Bean Lectin
2.5.1. Metal Ions Dependence
2.5.2. Thermal Stability of Zihua Snap Bean Lectin
2.5.3. pH Stability of Zihua Snap Bean Lectin
2.5.4. In Vitro Digestion Assay of Zihua Snap Bean Lectin
2.5.5. Antibacterial Experiment of Zihua Snap Bean Lectin
2.5.6. Antifungal Experiment of Zihua Snap Bean Lectin
2.6. Electrophoresis
2.7. Nano LC-ESI-MS/MS Analysis
2.8. Fourier Transform Infrared Sectroscopy
2.9. Fluorescence Spectroscopy
2.10. Statistical Analysis
3. Results and Discussion
3.1. Purification of Zihua Snap Bean Lectin
3.2. Identification of Zihua Snap Bean Lectin by Tandem Mass Spectrometry
3.2.1. Lectin Tape Analysis
3.2.2. Unknown Sample Tape Analysis
3.3. The Properties of Zihua Snap Bean Lectin
3.3.1. Carbohydrate Specificity of Zihua Snap Bean Lectin
3.3.2. Metal Ions’ Dependency of Zihua Snap Bean Lectin
3.3.3. Thermal Stability of the Zihua Snap Bean Lectin
3.3.3.1. Infrared Analysis
3.3.3.2. Fluorescence Spectroscopy Analysis
3.3.4. pH Stability of Zihua Snap Bean Lectin
3.4. In Vitro Studies of the Digestibility of Zihua Snap Bean Lectin
3.4.1. The Digestibility of Native Lectin In Vitro
3.4.2. The Digestibility of Thermal-Treated Lectin
3.5. Antimicrobial of Zihua Snap Bean Lectin
3.5.1. Antibacterial Activity of Zihua Snap Bean Lectin
3.5.2. Antifungal Activity of Zihua Snap Bean Lectin
4. Conclusions
Author Contributions
Funding
Conflicts of Interest
References
- Rubeena, A.S.; Divya, M.; Vaseeharan, B.; Karthikeyan, S.; Ringo, E.; Preetham, E. Antimicrobial and biochemical characterization of a C-type lectin isolated from pearl spot (Etroplus suratensis). Fish Shellfish Immunol. 2019, 87, 202–211. [Google Scholar] [CrossRef]
- Silva, M.C.C.; Santana, L.A.; Mentele, R.; Ferreira, R.S.; de Miranda, A.; Silva-Lucca, R.A.; Sampaio, M.U.; Correia, M.T.S.; Oliva, M.L.V. Purification, primary structure and potential functions of a novel lectin from Bauhinia forficata seeds. Process Biochem. 2012, 47, 1049–1059. [Google Scholar] [CrossRef]
- Lagarda-Diaz, I.; Guzman-Partida, A.M.; Urbano-Hernandez, G.; Ortega-Nieblas, M.M.; Robles-Burgueño, M.R.; Winzerling, J.; Vazquez-Moreno, L. Insecticidal Action of PF2 Lectin from Olneya tesota (Palo Fierro) against Zabrotes subfasciatus Larvae and Midgut Glycoconjugate Binding. J. Agric. Food Chem. 2009, 57, 689–694. [Google Scholar] [CrossRef]
- Li, J.; Qu, X.; Payne, G.F.; Zhang, C.; Zhang, Y.; Li, J.; Ren, J.; Hong, H.; Liu, C. Biospecific Self-Assembly of a Nanoparticle Coating for Targeted and Stimuli-Responsive Drug Delivery. Adv. Funct. Mater. 2015, 25, 1404–1417. [Google Scholar] [CrossRef]
- da Silva, J.S.; Oliveira, M.D.; de Melo, C.P.; Andrade, C.A. Impedimetric sensor of bacterial toxins based on mixed (Concanavalin A)/polyaniline films. Colloids Surf B Biointerfaces 2014, 117, 549–554. [Google Scholar] [CrossRef]
- Macedo, M.L.; das Graças Machado Freire, M.; da Silva, M.B.; Coelho, L.C. Insecticidal action of Bauhinia monandra leaf lectin (BmoLL) against Anagasta kuehniella (Lepidoptera: Pyralidae), Zabrotes subfasciatus and Callosobruchus maculatus (Coleoptera: Bruchidae). Comp. Biochem. Physiol. 2007, 146, 486–498. [Google Scholar] [CrossRef]
- Lagarda-Diaz, I.; Guzman-Partida, A.M.; Vazquez-Moreno, L. Legume Lectins: Proteins with Diverse Applications. Int. J. Mol. Sci. 2017, 18, 1242. [Google Scholar] [CrossRef] [PubMed]
- Mello Ede, O.; dos Santos, I.S.; Carvalho Ade, O.; de Souza, L.S.; de Souza-Filho, G.A.; do Nascimento, V.V.; Machado, O.L.; Zottich, U.; Gomes, V.M. Functional expression and activity of the recombinant antifungal defensin PvD1r from Phaseolus vulgaris L. (common bean) seeds. BMC Biochem. 2014, 15, 1–13. [Google Scholar] [CrossRef] [PubMed]
- Lusvarghi, S.; Bewley, C.A. Griffithsin: An Antiviral Lectin with Outstanding Therapeutic Potential. Viruses 2016, 8, 296. [Google Scholar] [CrossRef]
- Shen, L.; Luo, Z.; Wu, J.; Qiu, L.; Luo, M.; Ke, Q.; Dong, X. Enhanced expression of alpha2,3-linked sialic acids promotes gastric cancer cell metastasis and correlates with poor prognosis. Int. J. Oncol. 2017, 50, 1201–1210. [Google Scholar] [CrossRef] [PubMed]
- Blomme, B.; Van Steenkiste, C.; Callewaert, N.; Van Vlierberghe, H. Alteration of protein glycosylation in liver diseases. J. Hepatol. 2009, 50, 592–603. [Google Scholar] [CrossRef]
- Fekete, F.; Fadgyas, B.; Papp, E.; Szilagyi, A.; Prohaszka, Z.; Muller, B.; Kovacs, G. The role of mannose binding lectin on fever episodes in pediatric oncology patients. Pathol. Oncol. Res. 2016, 22, 139–143. [Google Scholar] [CrossRef]
- Nunes, B.S.; Rensonnet, N.S.; Dal-Secco, D.; Vieira, S.M.; Cavada, B.S.; Teixeira, E.H.; Moura, T.R.; Teixeira, C.S.; Clemente-Napimoga, J.T.; Cunha, F.Q.; et al. Lectin extracted from Canavalia grandiflora seeds presents potential anti-inflammatory and analgesic effects. Naunyn Schmiedebergs Arch. Pharmacol. 2009, 379, 609–616. [Google Scholar] [CrossRef] [PubMed]
- Nareddy, P.K.; Bobbili, K.B.; Swamy, M.J. Purification, physico-chemical characterization and thermodynamics of chitooligosaccharide binding to cucumber (Cucumis sativus) phloem lectin. Int. J. Biol. Macromol. 2017, 95, 910–919. [Google Scholar] [CrossRef] [PubMed]
- Zhang, J.S.; Shi, J.; Ilic, S.; Jun Xue, S.; Kakuda, Y. Biological Properties and Characterization of Lectin from Red Kidney Bean (Phaseolus Vulgaris). Food Rev. Int. 2008, 25, 12–27. [Google Scholar] [CrossRef]
- He, S.D.; Shi, J.; Walid, E.; Zhang, H.; Ma, Y.; Xue, S.J. Reverse micellar extraction of lectin from black turtle bean (Phaseolus vulgaris): Optimisation of extraction conditions by response surface methodology. Food Chem. 2015, 166, 93–100. [Google Scholar] [CrossRef]
- Jiang, B.; Na, J.X.; Wang, L.L.; Li, D.M.; Liu, C.H.; Feng, Z.B. Separation and Enrichment of Antioxidant Peptides from Whey Protein Isolate Hydrolysate by Aqueous Two-Phase Extraction and Aqueous Two-Phase Flotation. Foods 2019, 8, 34. [Google Scholar] [CrossRef]
- Wang, N.; Lewis, M.J.; Brennan, J.G.; Westby, A. Effect of processing methods on nutrients and anti-nutritional factors in cowpea. Food Chem. 1997, 58, 59–68. [Google Scholar] [CrossRef]
- Wickham, M.; Faulks, R.; Mills, C. In vitro digestion methods for assessing the effect of food structure on allergen breakdown. Mol. Nutr. Food Res. 2009, 53, 952–958. [Google Scholar] [CrossRef] [PubMed]
- Astwood, J.D.; Leach, J.N.; Fuchs, R.L. Stability of food allergens to digesyion in vitro. Nat. Biotechnol. 1996, 14, 1269–1273. [Google Scholar] [CrossRef]
- He, S.D.; Simpson, B.K.; Ngadi, M.O.; Ma, Y. In vitro studies of the digestibility of lectin from black turtle bean (Phaseolus vulgaris). Food Chem. 2015, 173, 397–404. [Google Scholar] [CrossRef]
- Wong, J.H.; Ng, T.B. Purification of a trypsin-stable lectin with antiproliferative and HIV-1 reverse transcriptase inhibitory activity. Biochem. Biophys. Res. Commun. 2003, 301, 545–550. [Google Scholar] [CrossRef]
- Xia, L.; Ng, T.B. A hemagglutinin with mitogenic activity from dark red kidney beans. J. Chromatogr. B Anal. Technol. Biomed. Life Sci. 2006, 844, 213–216. [Google Scholar] [CrossRef]
- He, S.; Shi, J.; Walid, E.; Ma, Y.; Xue, S.J. Extraction and purification of a lectin from small black kidney bean (Phaseolus vulgaris) using a reversed micellar system. Process Biochem. 2013, 48, 746–752. [Google Scholar] [CrossRef]
- Jiang, B.; Yuan, Y.; Zhang, X.; Feng, Z.B.; Liu, C.H. Separation and Enrichment of Lectin from Zihua Snap-Bean (Phaseolus vulgaris) Seeds by PEG 600-Ammonium Sulfate Aqueous Two-Phase System. Molecules 2017, 22, 1596. [Google Scholar] [CrossRef] [PubMed]
- Jiang, B.; Na, J.X.; Wang, L.L.; Li, D.M.; Liu, C.H.; Feng, Z.B. Eco-Innovation in Reusing Food By-Products: Separation of Ovalbumin from Salted Egg White Using Aqueous Two-Phase System of PEG 1000/(NH4)2SO4. Polymers (Basel) 2019, 11, 238. [Google Scholar] [CrossRef]
- Lee, S.Y.; Khoiroh, I.; Ling, T.C.; Show, P.L. Aqueous Two-Phase Flotation for the Recovery of Biomolecules. Sep. Purif. Rev. 2015, 45, 81–92. [Google Scholar] [CrossRef]
- Iqbal, M.; Tao, Y.; Xie, S.; Zhu, Y.; Chen, D.; Wang, X.; Huang, L.; Peng, D.; Sattar, A.; Shabbir, M.A.; et al. Aqueous two-phase system (ATPS): An overview and advances in its applications. Biol. Proc. Online 2016, 18, 18. [Google Scholar] [CrossRef] [PubMed]
- He, S.D.; Shi, J.; Ma, Y.; Xue, S.J.; Zhang, H.W.; Zhao, S.X. Kinetics for the thermal stability of lectin from black turtle bean. J. Food Eng. 2014, 142, 132–137. [Google Scholar] [CrossRef]
- Costa, R.M.P.B.; Vaz, A.F.M.; Oliva, M.L.V.; Coelho, L.C.B.B.; Correia, M.T.S.; Carneiro-da-Cunha, M.G. A new mistletoe Phthirusa pyrifolia leaf lectin with antimicrobial properties. Process Biochem. 2010, 45, 526–533. [Google Scholar] [CrossRef]
- Nascimento, C.O.; Costa, R.M.P.B.; Araújo, R.M.S.; Chaves, M.E.C.; Coelho, L.C.B.B.; Paiva, P.M.G.; Teixeira, J.A.; Correia, M.T.S.; Carneiro-da-Cunha, M.G. Optimized extraction of a lectin from Crataeva tapia bark using AOT in isooctane reversed micelles. Process Biochem. 2008, 43, 779–782. [Google Scholar] [CrossRef]
- Suzuki, T.; Abe, T.; Umehara, K.; Choi, J.H.; Hirai, H.; Dohra, H.; Kawagishi, H. Purification and characterization of a lectin from the mushroom Hypsizigus marmoreus. Mycoscience 2015, 56, 359–363. [Google Scholar] [CrossRef][Green Version]
- Nagae, M.; Soga, K.; Morita-Matsumoto, K.; Hanashima, S.; Ikeda, A.; Yamamoto, K.; Yamaguchi, Y. Phytohemagglutinin from Phaseolus vulgaris (PHA-E) displays a novel glycan recognition mode using a common legume lectin fold. Glycobiology 2014, 24, 368–378. [Google Scholar] [CrossRef]
- Brewer, C.F.; Brown, R.D.; Koenig, S.H. Metal ion binding and conformational transitions in concanavalin A: a structure-function study. J. Biomol. Struct. Dyn. 1983, 1, 961–997. [Google Scholar] [CrossRef] [PubMed]
- de Santana, M.A.; Santos, A.M.; Oliveira, M.E.; de Oliveira, J.S.; Baba, E.H.; Santoro, M.M.; de Andrade, M.H. A novel and efficient and low-cost methodology for purification of Macrotyloma axillare (Leguminosae) seed lectin. Int. J. Biol. Macromol. 2008, 43, 352–358. [Google Scholar] [CrossRef]
- Zhao, J.K.; Wang, H.X.; Ng, T.B. Purification and characterization of a novel lectin from the toxic wild mushroom Inocybe umbrinella. Toxicon 2009, 53, 360–366. [Google Scholar] [CrossRef]
- Wang, Y.F.; Wu, B.Y.; Shao, J.J.; Jia, J.X.; Tian, Y.Q.; Shu, X.; Ren, X.J.; Guan, Y. Extraction, purification and physicochemical properties of a novel lectin from Laetiporus sulphureus mushroom. Lwt 2018, 91, 151–159. [Google Scholar] [CrossRef]
- Carbonaro, M.; Nucara, A. Secondary structure of food proteins by Fourier transform spectroscopy in the mid-infrared region. Amino Acids 2010, 38, 679–690. [Google Scholar] [CrossRef] [PubMed]
- Shen, L.; Tang, C.H. Microfluidization as a potential technique to modify surface properties of soy protein isolate. Food Res. Int. 2012, 48, 108–118. [Google Scholar] [CrossRef]
- Kavitha, M.; Bobbili, K.B.; Swamy, M.J. Differential scanning calorimetric and spectroscopic studies on the unfolding of Momordica charantia lectin. Similar modes of thermal and chemical denaturation. Biochimie 2010, 92, 58–64. [Google Scholar] [CrossRef]
- Biswas, S.; Kayastha, A.M. Unfolding and refolding of leucoagglutinin (PHA-L), an oligomeric lectin from kidney beans (Phaseolus vulgaris). Biochim. Biophys. Acta 2004, 1674, 40–49. [Google Scholar] [CrossRef] [PubMed]
- Maurice, R.E.; Roxana, I. Thermodynamics of protein unfolding: questions pertinent to testing the validity of the two-state model. Biophys. Chem. 1997, 64, 175–197. [Google Scholar]
- Khan, F.; Ahmad, A.; Khan, M.I. Chemical, thermal and pH-induced equilibrium unfolding studies of Fusarium solani lectin. IUBMB Life 2007, 59, 34–43. [Google Scholar] [CrossRef]
- Jana, S.; Chaudhuri, T.K.; Deb, J.K. Effects of guanidine hydrochloride on the conformation and enzyme activity of streptomycin adenylyltransferase monitored by circular dichroism and fluorescence spectroscopy. Biochemistry (Moscow) 2006, 71, 1230–1237. [Google Scholar] [CrossRef]
- Silvestrini, V.C.; GonÇAlves, D.B.; Granjeiro, P.A. Anti-nutritional factors and digestibility of protein in Cayocar brasiliense seeds. Food Sci. Technol. 2017, 37, 632–639. [Google Scholar] [CrossRef]
- Grozdanovic, M.M.; Ostojic, S.; Aleksic, I.; Andjelkovic, U.; Petersen, A.; Gavrovic, J.M. Active actinidin retains function upon gastro-intestinal digestion and is more thermostable than the E-64-inhibited counterpart. J. Sci. Food Agric. 2014, 94, 3046–3052. [Google Scholar] [CrossRef]
- Diana, M.; Tatiana, S.; Vitalie, I.R. Calcium Ions Make Phytohemagglutinin Resistant to Trypsin Proteolysis. J. Agric. Food Chem. 2008, 56, 3764–3771. [Google Scholar]
- Santi-Gadelha, T.; de Almeida Gadelha, C.A.; Aragao, K.S.; de Oliveira, C.C.; Lima Mota, M.R.; Gomes, R.C.; de Freitas Pires, A.; Toyama, M.H.; de Oliveira Toyama, D.; de Alencar, N.M.; et al. Purification and biological effects of Araucaria angustifolia (Araucariaceae) seed lectin. Biochem. Biophys. Res. Commun. 2006, 350, 1050–1055. [Google Scholar] [CrossRef]
- Sunanta, R.; Wayakorn, N.; Montri, C. Interaction of a mulberry leaf lectin with a phytopathogenic bacterium, P. syringae pv mori. Plant Sci. 2001, 160, 739–744. [Google Scholar]
- da Silva, J.D.F.; da Silva, S.P.; da Silva, P.M.; Vieira, A.M.; de Araujo, L.C.C.; de Albuquerque Lima, T.; de Oliveira, A.P.S.; do Nascimento Carvalho, L.V.; da Rocha Pitta, M.G.; de Melo Rego, M.J.B.; et al. Portulaca elatior root contains a trehalose-binding lectin with antibacterial and antifungal activities. Int. J. Biol. Macromol. 2019, 126, 291–297. [Google Scholar] [CrossRef]
- Charungchitrak, S.; Petsom, A.; Sangvanich, P.; Karnchanatat, A. Antifungal and antibacterial activities of lectin from the seeds of Archidendron jiringa Nielsen. Food Chem. 2011, 126, 1025–1032. [Google Scholar] [CrossRef]
- Chen, J.; Liu, B.; Ji, N.; Zhou, J.; Bian, H.J.; Li, C.Y.; Chen, F.; Bao, J.K. A novel sialic acid-specific lectin from Phaseolus coccineus seeds with potent antineoplastic and antifungal activities. Phytomedicine 2009, 16, 352–360. [Google Scholar] [CrossRef] [PubMed]
- da Silva, P.M.; de Moura, M.C.; Gomes, F.S.; da Silva Trentin, D.; Silva de Oliveira, A.P.; de Mello, G.S.V.; da Rocha Pitta, M.G.; de Melo Rego, M.J.B.; Coelho, L.; Macedo, A.J.; et al. PgTeL, the lectin found in Punica granatum juice, is an antifungal agent against Candida albicans and Candida krusei. Int. J. Biol. Macromol. 2018, 108, 391–400. [Google Scholar] [CrossRef] [PubMed]

| Hits | Protein Molecular Weight/Da | Number of Peptides | Link | Relative Abundance |
|---|---|---|---|---|
| 1 | 29,742.25 | 246 | Q8RVX6 | 57.3% |
| 2 | 39,105.93 | 65 | V7BFT4 | 8.6% |
| 3 | 35,564.65 | 56 | V7AIB2 | 10.8% |
| 4 | 27,190.47 | 27 | P02873 | 6.1% |
| 5 | 36,314.02 | 26 | V7BPP1 | 2.9% |
| 6 | 97,527 | 26 | V7BX14 | 1.6% |
| 7 | 97,769.06 | 23 | V7BZK0 | 0.6% |
| 8 | 71,495.53 | 20 | V7C9P5 | 0.1% |
| Peptide Number | Amino Acid Sequence | m/z |
|---|---|---|
| 6046 | HIGIDVNSIK | 1094.61 |
| 6339 | TTTWDFVK | 996.49 |
| 6350 | LTNVNDNGEPTLSSLGR | 1785.89 |
| 7217 | DKGGLLGLFNNYK | 1437.76 |
| 7269 | GNVETNDVLSWSFASK | 1752.83 |
| 7304 | YDSNAHTVAVEFDTLYNVHWDPKPR | 2973.40 |
| 7329 | GGLLGLFNNYK | 1194.64 |
| 7503 | TTTWDFVKGENAEVLITYDSSTK | 2604.26 |
| 8487 | SVLPEWVIVGFTATTGITK | 2018.11 |
| 8669 | YDSNAHTVAVEFDTLYNVHWDPK | 2720.25 |
| 8877 | LSDGTTSEALNLANFALNQIL | 2204.13 |
| 9249 | LLVASLVYPSLK | 1301.80 |
| 11054 | DKGGLLGLFNNYK | 1437.76 |
| Hits | Protein Molecular Weight/Da | Number of Peptides | Login ID | Relative Abundance |
|---|---|---|---|---|
| 1 | 29,742.25 | 104 | gi|19773404| | 34.4% |
| 2 | 24,778.15 | 48 | gi|2780981| | 18.4% |
| 3 | 50,723.5 | 29 | gi|75708857| | 3.1% |
| 4 | 49,241.02 | 25 | gi|130169| | 2.8% |
| 5 | 49,483.71 | 19 | gi|351727923| | 0.3% |
| 6 | 71,980.77 | 17 | gi|356500683| | 0.4% |
| 7 | 97,136.89 | 16 | gi|351727843| | 1.1% |
| 8 | 47,824.05 | 15 | gi|374297913| | 0.7% |
| Peptide Number | m/z | Amino Acid Sequence |
|---|---|---|
| 6346 | 1094.61 | HIGIDVNSIK |
| 6451 | 1785.89 | LTNVNDNGEPTLSSLGR |
| 6580 | 996.49 | TTTWDFVK |
| 6741 | 1246.67 | FNETNLILQR |
| 6991 | 1323.69 | TSFIVSDTVDLK |
| 7279 7326 | 1752.83 1437.76 | GNVETNDVLSWSFASK DKGGLLGLFNNYK |
| 7410 | 1301.80 | LLVASLVYPSLK |
| 7444 | 2973.40 | YDSNAHTVAVEFDTLYNVHWDPKPR |
| 7496 | 1194.64 | GGLLGLFNNYK |
| 8307 | 2018.11 | SVLPEWVIVGFTATTGITK |
| 8634 | 2204.13 | LSDGTTSEALNLANFALNQIL |
| Temperature | α-Helix | β-Fold | β-Turn | β-Reverse | Random Curl |
|---|---|---|---|---|---|
| 25 °C | 12.85 ± 0.14 b | 40.43 ± 0.11 a | 29.22 ± 0.12 d | 3.85±0.08 c | 13.60 ± 0.16 a |
| 70 °C | 12.84 ± 0.13 b | 42.23 ± 0.08 d | 27.68 ± 0.17 c | 3.39±0.11 b | 13.64 ± 0.15 a |
| 80 °C | 12.6 ± 0.19 b | 42.68 ± 0.13 e | 27.87 ± 0.15 c | 3.23±0.13 ab | 13.69 ± 0.08 a |
| 90 °C | 11.65 ± 0.17 a | 41.74 ± 0.15 c | 25.59 ± 0.14 b | 3.13±0.14a | 17.87 ± 0.11 b |
| 100 °C | 11.58 ± 0.11 a | 40.76 ± 0.19 b | 23.86 ± 0.09 a | 3.82±0.17 c | 19.98 ± 0.19 c |
| Bacterial | Different Addition Amount (µg) | Inhibition Halo (mm) |
|---|---|---|
| S. aureus (G+) | 10 | 10.5 ± 0.5 |
| 20 | 12.1 ± 0.8 | |
| 50 | 14.5 ± 1.1 | |
| E. coli (G−) | 10 | 8.2 ± 0.8 |
| 20 | 10.1 ± 0.8 | |
| 50 | 11.6 ± 0.5 | |
| B. subtilis (G+) | 10 | 8.8 ± 1.0 |
| 20 | 10.70 ± 0.5 | |
| 50 | 12.7 ± 0.7 |
© 2019 by the authors. Licensee MDPI, Basel, Switzerland. This article is an open access article distributed under the terms and conditions of the Creative Commons Attribution (CC BY) license (http://creativecommons.org/licenses/by/4.0/).
Share and Cite
Jiang, B.; Wang, X.; Wang, L.; Lv, X.; Li, D.; Liu, C.; Feng, Z. Two-Step Isolation, Purification, and Characterization of Lectin from Zihua Snap Bean (Phaseolus vulgaris) Seeds. Polymers 2019, 11, 785. https://doi.org/10.3390/polym11050785
Jiang B, Wang X, Wang L, Lv X, Li D, Liu C, Feng Z. Two-Step Isolation, Purification, and Characterization of Lectin from Zihua Snap Bean (Phaseolus vulgaris) Seeds. Polymers. 2019; 11(5):785. https://doi.org/10.3390/polym11050785
Chicago/Turabian StyleJiang, Bin, Xiaojing Wang, Linlin Wang, Xiaomeng Lv, Dongmei Li, Chunhong Liu, and Zhibiao Feng. 2019. "Two-Step Isolation, Purification, and Characterization of Lectin from Zihua Snap Bean (Phaseolus vulgaris) Seeds" Polymers 11, no. 5: 785. https://doi.org/10.3390/polym11050785
APA StyleJiang, B., Wang, X., Wang, L., Lv, X., Li, D., Liu, C., & Feng, Z. (2019). Two-Step Isolation, Purification, and Characterization of Lectin from Zihua Snap Bean (Phaseolus vulgaris) Seeds. Polymers, 11(5), 785. https://doi.org/10.3390/polym11050785

